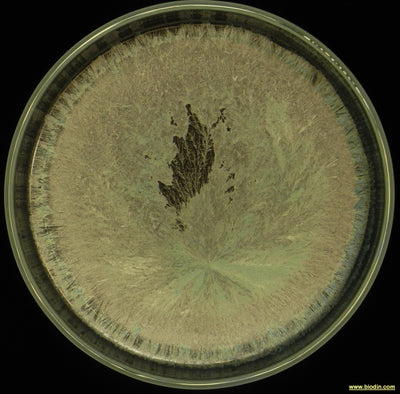
520 CORNO OSSIDIANA

BIODYNAMIC PREPARATIONS
Preparations developed for biodynamic agriculture to stimulate growth and maturation processes by connecting the soil and consequently the plant to the vital flows of both the Earth and the Cosmos based on the specific conditions that the farmer observes in the land and crops entrusted to him/her, rebalancing deficiencies or excesses where necessary.
Filter and sort
€15,00 EUR